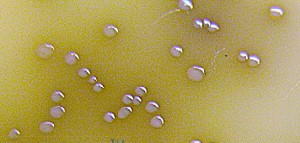

|
| 站点首页 | 关于我们 | 产品中心 | 新闻中心 | 企业新闻 | 资源下载 | 人才招聘 | 信息反馈 | 联系我们 | ||||||||
|
|
|||||||||||||||||||||||||||||||||||||||||||||||||||||||||||||||||||||||
|
广州标迈生物科技版权所有© 2006-2018 中国 • 广州 • 海珠区宝岗路四间巷32号南中商务楼608 粤ICP备08014008号
销售中心:020-83690735 图文传真:020-34204472 售后客服:18022458697 E-mail:abcsales@yeah.net 邮政编码:510300 |
|